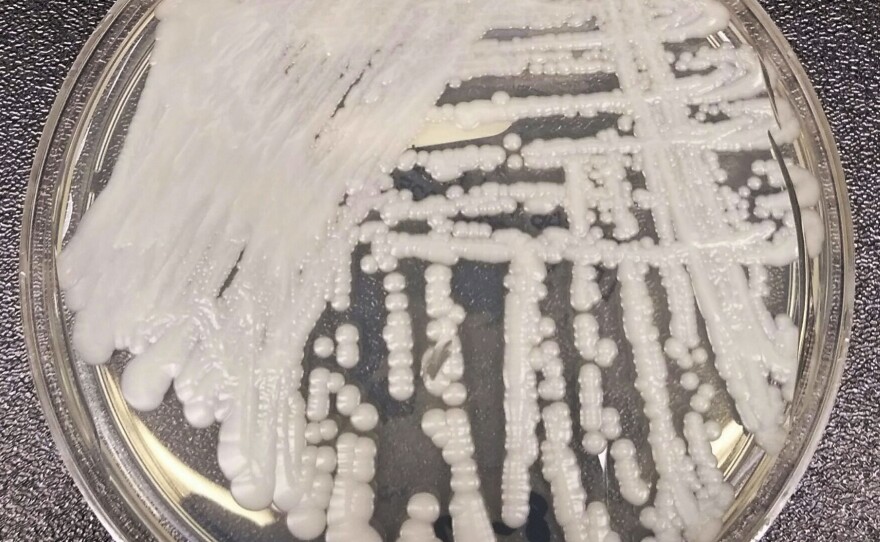
This is a strain of Candida auris cultured in a petri dish at a laboratory at the Centers for Disease Control and Prevention. It's a form of yeast that can harm humans — and is resistant to the most common antifungal drugs.

Combatting bacterial and viral infections is getting tougher because of their growing resistance to drugs. Antibiotic drugs can no longer be counted on to conquer nasty bacteria. Antivirals don't always overpower the viruses. This is a huge problem but it is one that widely acknowledged and researched.
There's an additional medical challenge though, that matters a lot. Namely, drug-resistant fungi.
Yep, fungi.
It's a topic that doesn't get discussed much — and that worries Paul Verweij, professor of clinical mycology at Radboud University Medical Center in Nijmegen, the Netherlands. He says there's a "silence surge" in drug-resistant fungi and that it's mostly happening under-the-radar.
This is a particular challenge in lower-income countries.
"Look at, for instance, Candida auris [a type of yeast that can cause severe infections and is often drug-resistant] -- you need very, very strict infection control measures in hospitals, you need good diagnostics, good infection control, you have to follow-up with patients and that's just not available in these lower- middle-income countries," he says. "People will die, and you won't know they have a fungal infection. You wouldn't know if it was resistant."
Verweij teamed up with 50 scientists around the world – from Brazil to Nigeria to China — to call for action against drug‑resistant fungi in Nature Medicine this week.
NPR spoke with Verweij, who's been working on this issue for more than 20 years. His interview has been edited for length and clarity.
What's the link between agriculture and drug-resistant fungi?
Fungicides are used to protect plants against fungal disease. Everything — watermelons, maize, wheat, flowers — use lots of fungicides. If we didn't use the fungicides, you'd probably have a yield loss maybe of 30% or 40%.
The problem is that the fungicides are quite similar to the drugs we give to patients. So the fungus becomes resistant to the fungicide and, at the same time, our medical azoles [a class of antifungal drugs] do not work as well anymore.
The fungi which cause disease in humans are not causing disease in plants. So this is an unintended effect.
How does the resistance get from farms to hospitals?
So the molds – the hairy fungi – have spores which are released into the air. These spores travel long distances. It's not really well-understood but the idea is that they go right up to these jet streams, very high into the atmosphere and then can travel for continents. We inhale the spores all the time.
How serious are fungal infections?
With fungi you have two types of infections. First, we have very severe infections, and they usually occur in [hospitalized] patients who have some kind of defect in their immunity. So, yeast found in the bloodstream or mold in the lungs. Second, we have infections of the skin, the hair and the nails, which are irritating but are not life threatening.
In the past 10 to 20 years, we see more and more resistance in fungi in both those categories.
There are very few studies looking at the clinical impact. We did a study in the Netherlands, and we found that if you compare an infection [where azole antifungal drugs work] and where it's resistant. There's about a 20% difference in mortality — you're 20% more likely to die. So that's a significant impact. And there's the new skin disease [Trichophyton indotineae] where you don't have mortality but we've had patients who have been on treatment for four years and are still suffering from the infection.
Why is it hard to create new antifungals?
The main challenge is that fungi, if you look at the cell structure — how they are built up — it's very similar to the human cell. This is different from bacteria, because bacteria are much simpler. And viruses are even more simple because they don't even have a cell.
For fungi, because they're similar to human cells, it's quite difficult to find a drug which kills the fungus but does not harm the human cell. So in the past 75 years, we have developed only five classes of antifungals. The azoles are, by far, the most important.
The problem is that if you can't use one of these classes then maybe you'll have one alternative left. It's already causing problems. For instance, if the fungus is in the brain, you have a very few drugs which actually get into the brain.
What can be done?
At a mycology meeting we found a global community who wanted to collaborate [on this issue].
For example, you really want to know what people are using [on crops] and see if you can reduce that or if there's any unnecessary use. Another important factor is: If you introduce new fungicides, they [should] undergo an assessment to see their impact on human fungal pathogens. It's important to establish if there's a risk for cross resistance.
Are you optimistic?
I've worked in this field for a long time, and I think that it is changing.
WHO published a fungal pathogen list in 2022 for the first time — that had a major impact. A decade ago, when the World Health Organization came out with its global action plan against antimicrobial resistance, fungi were only mentioned twice. Now, after 10 years, it is being revised. And as a mycology community, we feel it is really important now that fungi are addressed.
The problem is, in fungi, we need to do the basic stuff: Develop the tools. Do the surveillance. Set up the [laboratory] networks. And it's sometimes difficult to get these basic things funded.
But overall, I think it's really changing. People are realizing this is not a local problem — it's really global.
Copyright 2026 NPR